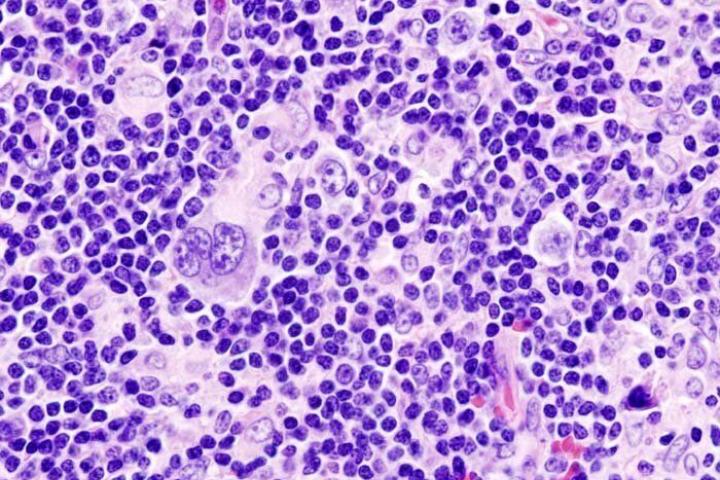

Qué es el linfoma de Hodgkin, el cáncer de Dani Rovira y Carla Suárez
Más de cinco meses después de que el actor anunciase su enfermedad publicando en Instagram una foto de su primera sesión de quimioterapia, la tenista ha comunicado la noticia en redes sociales.
La noticia llegó en marzo: Dani Rovira tiene cáncer. El actor fue muy claro en redes sociales, donde contó a sus seguidores que había sido diagnosticado de un linfoma de Hodgkin. “Hoy es mi primer día de quimio y (tengo) por delante una larga lucha contra el bicho. No tengo miedo. Estoy tranquilo”, escribió el día 25 en Instagram junto a una foto de esa primera sesión. Más de cinco meses después y sólo dos semanas más tarde de que Rovira haya anunciado su recuperación, la noticia ha llegado de la tenista Carla Suárez. “Los médicos me detectaron hace unos días un linfoma de Hodgkin que requiere de quimioterapia”, dijo la deportista el martes 1 de septiembre en Instagram.
El linfoma de Hodgkin es un subtipo de linfoma, una enfermedad oncohematológica. Este grupo lo forman las enfermedades en las que las células que se malignizan son células que están en la sangre como ocurre con la leucemia (leucocitos o glóbulos blancos).
En el caso de los linfomas, las células afectadas son los linfocitos, un tipo de glóbulos blancos con una papel muy importante para nuestras defensas. A partir de aquí hay dos tipos de linfomas:
- Linfomas de Hodgkin (LH), también llamada Enfermedad de Hodgkin EH).
- Linfomas No Hodgkin (LNH).
Según señala en su web la Asociación Española Contra el Cáncer (AECC), el linfoma de Hodgkin se origina cuando los mecanismos de control de los linfocitos se alteran, entonces se inicia una división celular anómala e incontrolada, y así es como se empieza a producir el linfoma de Hodgkin..
No es un cáncer demasiado frecuente en términos generales. En 2018 se diagnosticaron en España 8.765 casos de cáncer de tejido linfático (linfomas) y, según la AECC, “el linfoma de Hodgkin supone el 10% de los linfomas”. A nivel mundial ese año se estimó una incidencia de 79.990 nuevos casos.
Lo que sí es un cáncer frecuente en las edades más jóvenes. Según la Sociedad Española de Hematología y Hemoterapia (SEHH), es el más frecuente en adolescentes y adultos jóvenes (15-30 años). De hecho su distribución en España es bimodal, con un pico en jóvenes adultos (alrededor de los 20 años) y otro en pacientes de edad más avanzada (alrededor de los 65 años).
El de Dani Rovira tiene un buen pronóstico, según palabras del actor. “Los doctores me transmiten muy buenas sensaciones”, asegura en Instagram siendo consciente de los peligros. “Eso sí, pasaré a formar parte de esa población de alto riesgo cuando las defensas y el sistema inmunitario empiecen a fallarme en unos días, así que tendré que cuidarme, cuidar y dejarme cuidar un poco más”, apunta en relación a la pandemia por coronavirus, que sitúa a los enfermos de cáncer como grupo vulnerable.
Según apunta la SEHH, entre el 80 y 90% de los pacientes de linfoma de Hodgkin alcanza la curación.